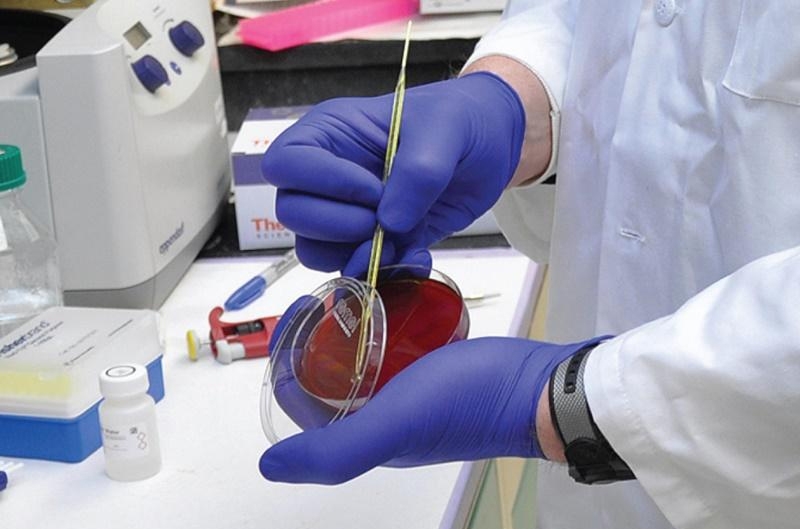
&Rho;&alpha;&pi;&tau;ά&kappa;&eta; &Phi;&iota;&lambda;ί&tau;&sigma;&alpha;

| Στοιχεία επιχείρησης | |
| Επωνυμία: | Hotel Μάνθος / Ξενοδοχείο Μάνθος |
| Υπεύθυνος: | Ντίνα Ιωάννα |
| Διεύθυνση: | Ελ. Βενιζέλου 44, 59300 Αλεξάνδρεια Ημαθίας |
| Ωράριο: | Πάντα ανοιχτά |
| Κατηγορία: | Ξενοδοχεία |
| Προϊόντα/Υπηρεσίες: | Καφέ-μπαρ, 36 ολοκαίνουργια και υψηλής αισθητικής δωμάτια, |
| 2 σουίτες (mini & president), ιδιωτικό πάρκινγκ |
| Επικοινωνία |

Το ξενοδοχείο ΜΑΝΘΟΣ άρχισε να λειτουργεί στην πρώτη του μορφή από το 1967, και είναι το πρώτο ξενοδοχείο του νομού Ημαθίας. Τον Ιούνιο του 2003 ξεκίνησε η ριζική ανακαίνισή του, η οποία ολοκληρώθηκε τον Απρίλιο του 2005. Με την τρέχουσα μορφή του και το αναβαθμισμένο ποιοτικό όφελος των υπηρεσιών, το ξενοδοχείο μας μπορεί να σας ψυχαγωγεί με τις καλύτερες συνθήκες διαμονής.
Σε 36 ολοκαίνουργια και υψηλής αισθητικής δωμάτια θα βρείτε ηρεμία και όλες τις σύγχρονες ανέσεις για μια ευχάριστη διαμονή. Η διεύθυνση και το προσωπικό του ξενοδοχείου μας είναι πάντα έτοιμοι να σας εξυπηρετήσουν και να νιώσετε την ευχάριστη αίσθηση της φιλοξενίας του ξενοδοχείου μας.
Το ξενοδοχείο μας διαθέτει 2 σουίτες (mini & president). Είναι δύο ξεχωριστοί χώροι οι οποίοι δημιουργήθηκαν με ιδιαίτερο μεράκι, φροντίδα και πολυτέλεια, με σκοπό να νιώσουν οι φιλοξενούμενοι μοναδικοί και ξεχωριστοί. Οι σουίτες διαθέτουν επιπλέον jacujji, mini office και ιδιωτικό σαλόνι. Όλα τα δωμάτια είναι λειτουργικά, διαθέτουν κλιματισμό, ατομικό μπάνιο ή ντους, στεγνωτήρα μαλλιών, μίνι μπαρ, ιδιωτικό μπαλκόνι, τηλέφωνο άμεσης σύνδεσης και πρόσβαση στο διαδίκτυο.
Το πρωί θα σερβιριστεί η πλήρης ποικιλία γεύσεων στο πρωινό σας, το απόγευμα πίνετε τον καφέ σας στο καφέ-μπαρ και το βράδυ χαλαρώνετε πίνοντας ένα ποτό δίπλα στο τζάκι.
Το ξενοδοχείο διαθέτει επίσης ιδιωτικό πάρκινγκ.
Το ξενοδοχείο MANTHOS βρίσκεται στο κέντρο του αρχαιολογικού ενδιαφέροντος τριγώνου, Πέλλας, Βεργίνας, Δίον, αποτελώντας έτσι ιδανικό εφαλτήριο για αρχαιολογικές εξορμήσεις και εκπαιδευτικές εκδρομές.
Επίσης το ξενοδοχείο, βρίσκεται πολύ κοντά στα χιονοδρομικά κέντρα Σέλι και 3-5 Πηγάδια.










| Επικοινωνία |

| Στοιχεία επιχείρησης | |
| Επωνυμία: | Κέντρο Ξένων Γλωσσών Γιαννοπούλου Ελισσάβετ |
| Υπεύθυνοι: | Γιαννοπούλου Ελισσάβετ |
| Διεύθυνση: |
Βιζυηνού 34, Αλεξάνδρεια, Τ.Κ. 59300 |
| Ωράριο: |
Εγγραφές καθημερινά από 5μμ. εως 8μμ. |
| Κατηγορία: | Φροντιστήρια ξένων γλωσσών |
| Προϊόντα/Υπηρεσίες: |
Κέντρο Ξένων Γλωσσών
|
Κέντρο Ξένων Γλωσσών Γιαννοπούλου Ελισσάβετ: Η πόρτα σας στον κόσμο της αγγλικής γλώσσας
Στην καρδιά της Αλεξάνδρειας, το Κέντρο Ξένων Γλωσσών Γιαννοπούλου Ελισσάβετ προσφέρει ένα μοναδικό και αποτελεσματικό περιβάλλον μάθησης για όλες τις ηλικίες. Με μακρόχρονη εμπειρία στον τομέα της διδασκαλίας της αγγλικής γλώσσας, η κα Γιαννοπούλου και η ομάδα της έχουν καταφέρει να βοηθήσουν χιλιάδες μαθητές να επιτύχουν τους γλωσσικούς τους στόχους.
Γιατί να επιλέξετε το Κέντρο Ξένων Γλωσσών Γιαννοπούλου Ελισσάβετ;
- Προσωποποιημένη διδασκαλία: Τα μαθήματα προσαρμόζονται στις ανάγκες και τις δυνατότητες κάθε μαθητή, εξασφαλίζοντας τη μέγιστη απόδοση.
- Έμπειροι καθηγητές: Η ομάδα των καθηγητών αποτελείται από έμπειρους επαγγελματίες με εξειδίκευση στη διδασκαλία της αγγλικής ως ξένης γλώσσας.
- Πλούσιο εκπαιδευτικό υλικό: Χρησιμοποιούνται σύγχρονα εκπαιδευτικά μέσα και υλικά για να κάνουν τα μαθήματα διαδραστικά και ευχάριστα.
- Φιλικό περιβάλλον: Το ζεστό και φιλικό περιβάλλον του κέντρου δημιουργεί ένα ιδανικό χώρο για μάθηση και κοινωνικοποίηση.
- Επιτυχία: Τα υψηλά ποσοστά επιτυχίας των μαθητών μαρτυρούν την ποιότητα της διδασκαλίας.
Τι προσφέρουμε:
- Μαθήματα για όλες τις ηλικίες: όλοι μπορούν να βρουν το κατάλληλο πρόγραμμα.
- Προετοιμασία για εξετάσεις: Προσφέρουμε εξειδικευμένα μαθήματα για όσους επιθυμούν να προετοιμαστούν για εξετάσεις
- Εταιρικά προγράμματα: Παρέχουμε εξατομικευμένα προγράμματα για εταιρείες που επιθυμούν να βελτιώσουν τις γλωσσικές δεξιότητες των εργαζομένων τους.
Επικοινωνήστε μαζί μας για να μάθετε περισσότερα και να κλείσετε μια δωρεάν δοκιμαστική επίσκεψη.
| Επικοινωνία |
|
|

| Στοιχεία επιχείρησης | |
| Επωνυμία: | AIR Travel |
| Υπεύθυνος: | Σιαφάλου Γεωργία |
| Διεύθυνση: | Δ. Βετσοπούλου 82, 59300 Αλεξάνδρεια Ημαθίας |
| Ωράριο: | Ωράριο καταστημάτων |
| Κατηγορία: | Τουριστικά γραφεία |
| Προϊόντα/Υπηρεσίες: | Πακέτα εκδρομών, αεροπορικά και ακτοπλοικά εισιτήρια, ξεναγήσεις, |
| γαμήλια ταξίδια, εξωτικά ταξίδια, ενοικιαζόμενα αυτοκίνητα και βίζες |
| Επικοινωνία |
Το ταξιδιωτικό γραφείο ''Σιαφάλου'' βρίσκεται στην καρδιά της Αλεξάνδρειας και λειτουργεί με επιτυχία για πάνω από 25 χρόνια, προσφέροντας μια ευρεία γκάμα ταξιδιωτικών υπηρεσιών που καλύπτουν όλες τις ανάγκες των πελατών του. Με την πολυετή εμπειρία και την εξειδίκευση του προσωπικού, το γραφείο ''Σιαφάλου'' έχει εδραιωθεί ως ένας από τους πιο αξιόπιστους και αγαπητούς ταξιδιωτικούς πράκτορες στην περιοχή.
Υπηρεσίες που προσφέρει:
-
Αεροπορικά Εισιτήρια: Το γραφείο ''Σιαφάλου'' συνεργάζεται με όλες τις μεγάλες αεροπορικές εταιρείες, εξασφαλίζοντας στους πελάτες του τις καλύτερες τιμές και δρομολόγια. Είτε πρόκειται για επαγγελματικά ταξίδια είτε για αναψυχή, το γραφείο αναλαμβάνει την εύρεση και κράτηση των αεροπορικών εισιτηρίων που ταιριάζουν στις ανάγκες σας.
-
Ακτοπλοϊκά Εισιτήρια: Με πολυετή εμπειρία στον τομέα των ακτοπλοϊκών μεταφορών, το γραφείο ''Σιαφάλου'' παρέχει εισιτήρια για όλα τα δρομολόγια των ελληνικών νησιών, εξασφαλίζοντας άνετη και ασφαλή μετακίνηση για τους πελάτες του.
-
Εκδρομικά Πακέτα: Το γραφείο σχεδιάζει και προσφέρει εκδρομικά πακέτα τόσο στην Ελλάδα όσο και στο εξωτερικό. Τα πακέτα αυτά περιλαμβάνουν μεταφορά, διαμονή και ξεναγήσεις σε δημοφιλείς προορισμούς, προσφέροντας μια ολοκληρωμένη ταξιδιωτική εμπειρία.
-
Κρατήσεις Ξενοδοχείων: Το ταξιδιωτικό γραφείο ''Σιαφάλου'' συνεργάζεται με ξενοδοχεία σε όλο τον κόσμο, προσφέροντας στους πελάτες του ποιοτικές επιλογές διαμονής που ανταποκρίνονται στις προτιμήσεις και το budget τους.
-
Ημερήσιες Εκδρομές: Για εκείνους που επιθυμούν σύντομες αποδράσεις, το γραφείο ''Σιαφάλου'' οργανώνει ημερήσιες εκδρομές σε διάφορους προορισμούς εντός Ελλάδας, καθώς και σε κοντινές χώρες, παρέχοντας μια ξεχωριστή εμπειρία γεμάτη εξερεύνηση και διασκέδαση.
Γιατί να επιλέξετε το ταξιδιωτικό γραφείο ''Σιαφάλου'':
- Πολυετής Εμπειρία: Με πάνω από 25 χρόνια στον χώρο, το γραφείο γνωρίζει τις ανάγκες των ταξιδιωτών και προσφέρει λύσεις που ικανοποιούν ακόμα και τους πιο απαιτητικούς πελάτες.
- Προσωπική Εξυπηρέτηση: Το εξειδικευμένο προσωπικό είναι πάντα στη διάθεσή σας για να σας βοηθήσει να σχεδιάσετε το ιδανικό ταξίδι, προσφέροντας εξατομικευμένες προτάσεις και λύσεις.
- Αξιοπιστία: Με σταθερή παρουσία στην αγορά, το γραφείο ''Σιαφάλου'' έχει κερδίσει την εμπιστοσύνη των πελατών του, παρέχοντας ασφαλείς και ποιοτικές υπηρεσίες.
Το ταξιδιωτικό γραφείο ''Σιαφάλου'' είναι ο ιδανικός συνεργάτης για κάθε σας ταξίδι, προσφέροντας ολοκληρωμένες υπηρεσίες και μοναδικές ταξιδιωτικές εμπειρίες. Επισκεφθείτε μας στην Αλεξάνδρεια και αφήστε μας να σας βοηθήσουμε να σχεδιάσετε το επόμενο αξέχαστο ταξίδι σας!





| Επικοινωνία |

Δρ Γκιουρτζής Στέφανος, παιδίατρος, διδάκτωρ Αριστοτελείου Πανεπιστημίου Θεσσαλονίκης - Παιδιατρικό ιατρείο στην Αλεξάνδρεια Ημαθίας.

Με εμπειρία δεκαετιών, δίπλα σας με γνώση και ανθρωπιά.
Στην Αλεξάνδρεια, το όνομα του Γιάννη Γκιουρτζή είναι συνώνυμο της συνέπειας και της φροντίδας. Με δεκαετίες παρουσίας στον χώρο της οδοντιατρικής, προσφέρει λύσεις που στηρίζονται στην επιστήμη, αλλά εφαρμόζονται με ανθρώπινο μέτρο.
Αναλαμβάνει με υπευθυνότητα:
-
Εξαγωγές δοντιών και επεμβάσεις στόματος
-
Αντιμετώπιση ουλίτιδας και περιοδοντίτιδας
-
Όψεις πορσελάνης και αισθητικές αποκαταστάσεις
-
Ορθοδοντικές εφαρμογές (σιδεράκια – παιδιά & ενήλικες)
Αν ψάχνετε έναν γιατρό που να σας ακούει, να σας εξηγεί και να σας εμπνέει εμπιστοσύνη, ίσως δεν χρειάζεται να ψάξετε μακριά.
???? Στην καρδιά της Αλεξάνδρειας. Γιατί το χαμόγελο… έχει ιστορία.
Δελιόπουλος Στέφανος - Χειρουργός οδοντίατρος και ειδικός ορθοδοντικός.
Ορθοδοντική για ενήλικες και παιδιά, αισθητικά brackets και αισθητικοί νάρθηκες.
Αλεξάνδρεια Ημαθίας.
Το οδοντιατρείο "Δελιόπουλος Στέφανος" αποτελεί έναν από τους πιο αξιόπιστους προορισμούς για οδοντιατρική φροντίδα στην Αλεξάνδρεια. Με παρουσία πάνω από δύο δεκαετίες, το οδοντιατρείο συνεχίζει την παράδοση της εξαιρετικής οδοντιατρικής φροντίδας που ξεκίνησε ο πατέρας του, Αντώνιος Δελιόπουλος. Ο Αντώνιος Δελιόπουλος, με πάνω από 40 χρόνια εμπειρίας στον τομέα της οδοντιατρικής, ίδρυσε το οδοντιατρείο με όραμα να προσφέρει υψηλού επιπέδου υπηρεσίες στους ασθενείς του.
Ο Στέφανος Δελιόπουλος, ως δεύτερη γενιά οδοντιάτρων, διατηρεί και εξελίσσει το έργο του πατέρα του, συνδυάζοντας την πλούσια οικογενειακή παράδοση με τις σύγχρονες τεχνικές και τεχνολογίες στην οδοντιατρική. Με έμφαση στην πρόληψη, την αποκατάσταση και την αισθητική οδοντιατρική, το οδοντιατρείο προσφέρει ολοκληρωμένες λύσεις για τη στοματική υγεία, προσαρμοσμένες στις ανάγκες κάθε ασθενούς.
Η δέσμευση στην ποιότητα και την προσωπική φροντίδα είναι αυτό που διακρίνει το οδοντιατρείο "Δελιόπουλος Στέφανος". Με σεβασμό στην ιστορία του και βλέμμα στραμμένο στο μέλλον, το οδοντιατρείο συνεχίζει να αποτελεί σημείο αναφοράς για την τοπική κοινότητα, προσφέροντας υπηρεσίες που ανταποκρίνονται στις υψηλότερες απαιτήσεις της σύγχρονης οδοντιατρικής.

| Στοιχεία επιχείρησης | |
| Επωνυμία: | Μικροβιολογικό εργαστήριο - Αμοιρίδου |
| Υπεύθυνοι: | Αμοιρίδου Κυριακή |
| Διεύθυνση: |
Δ. Βετσοπούλου, 68 - Τ.Κ. 59300 - Αλεξάνδρεια Ημαθίας |
| Ωράριο: |
Δέχεται πρωινά από 08:00 έως 14:00 |
| Κατηγορία: | Μικροβιολογικά εργαστήρια |
| Προϊόντα/Υπηρεσίες: |
Αιματολογικό, Βιοχημικό, Ορμονολογικό, Ανοσολογικό, Αλλεργιών, Γονιμότητας, Προγεννητικός |
| Επικοινωνία |
|
|


| Στοιχεία επιχείρησης | |
| Επωνυμία: | Ραπτάκη |
| Υπεύθυνοι: | Ραπτάκης Φιλίτσα |
| Διεύθυνση: | Θεμ. Σοφούλη 30, 59300 - Αλεξάνδρεια Ημαθίας |
| Ωράριο: |
Δέχεται πρωινά από 08:00 έως 14:00 Απογεύματα Δευτέρας - Τετάρτης: από 18:00 έως 20:00 |
| Κατηγορία: | Μικροβιολογικά εργαστήρια |
| Προϊόντα/Υπηρεσίες: |
Αιματολογικό, Βιοχημικό, Ορμονολογικό, Ανοσολογικό, Αλλεργιών, Γονιμότητας, Προγεννητικός
|
Παπακωνσταντίνου-Ραπτάκη Φιλίτσα - Ιατρός μικροβιολόγος και βιοπαθολόγος, μικροβιολογικό εργαστήριο.
Αλεξάνδρεια Ημαθίας.
Το Μικροβιολογικό Εργαστήριο Φιλίτσας Ραπτάκη, που βρίσκεται στην Αλεξάνδρεια, στην οδό Θεμιστοκλή Σοφούλη 30, αποτελεί σημείο αναφοράς στον τομέα των ιατρικών εξετάσεων από το 1986. Υπό την ηγεσία της κυρίας Φιλίτσας Ραπτάκη, Ιατρού Μικροβιολόγου και Βιοπαθολόγου, το εργαστήριο προσφέρει εξειδικευμένες και αξιόπιστες υπηρεσίες στους ασθενείς του.
Το εργαστήριο είναι εξοπλισμένο με σύγχρονα μηχανήματα και ακολουθεί αυστηρά πρωτόκολλα για την εξασφάλιση της ακρίβειας και της αξιοπιστίας των αποτελεσμάτων. Οι υπηρεσίες που παρέχονται καλύπτουν ένα ευρύ φάσμα εξετάσεων, περιλαμβάνοντας:
- Αιματολογικό έλεγχο: Ανάλυση αίματος για τη διάγνωση και την παρακολούθηση διάφορων ασθενειών.
- Βιοχημικό έλεγχο: Μετρήσεις διαφόρων χημικών ουσιών στο αίμα για την αξιολόγηση της λειτουργίας των οργάνων.
- Ορμονολογικό έλεγχο: Έλεγχος των επιπέδων ορμονών για τη διάγνωση ενδοκρινολογικών διαταραχών.
- Ανοσολογικό έλεγχο: Αξιολόγηση της λειτουργίας του ανοσοποιητικού συστήματος.
- Έλεγχος αλλεργιών: Δοκιμές για τον εντοπισμό αλλεργιών σε διάφορες ουσίες.
- Έλεγχος γονιμότητας: Εξετάσεις για την αξιολόγηση της γονιμότητας τόσο στους άνδρες όσο και στις γυναίκες.
- Προγεννητικός έλεγχος: Εξετάσεις για την παρακολούθηση της υγείας της εγκύου και του εμβρύου κατά τη διάρκεια της εγκυμοσύνης.
- Μοριακή βιολογία: Προηγμένες τεχνικές για τη διάγνωση και την παρακολούθηση γενετικών και λοιμωδών νοσημάτων.
Με έμφαση στην επιστημονική ακεραιότητα και την ανθρώπινη προσέγγιση, το Μικροβιολογικό Εργαστήριο Φιλίτσας Ραπτάκη διασφαλίζει την παροχή υψηλού επιπέδου υπηρεσιών υγείας στην τοπική κοινότητα και όχι μόνο. Το έμπειρο και φιλικό προσωπικό του εργαστηρίου είναι πάντα έτοιμο να εξυπηρετήσει τους ασθενείς με επαγγελματισμό και κατανόηση, διασφαλίζοντας την καλύτερη δυνατή φροντίδα.
| Επικοινωνία |
|
|

Πασχώνη Φλώρα - Ιατρός μικροβιολόγος και βιοπαθολόγος, μικροβιολογικό εργαστήριο.
Αιματολογικό, βιοχημικό, ορμονολογικό, ανοσολογικό, προγεννετικός έλεγχος, έλεγχος γονιμότητας, σύμβαση με ΕΟΠΠΥ.
Αλεξάνδρεια Ημαθίας.
Warning: count(): Parameter must be an array or an object that implements Countable in /home/odig/public_html/templates/ja_directory/html/com_k2/default/user.php on line 267